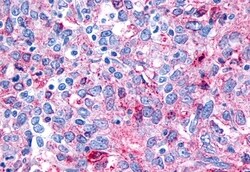
Invitrogen FZD8 Polyclonal Antibody 50 &mu;g; Unconjugated:Antibodies,
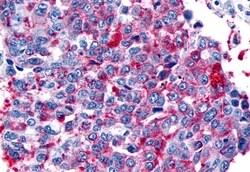
Invitrogen FZD8 Polyclonal Antibody 50 &mu;g; Unconjugated:Antibodies,

Promotional price valid on web orders only. Your contract pricing may differ. Interested in signing up for a dedicated account number?
Learn More
Learn More
Invitrogen™ FZD8 Polyclonal Antibody


Rabbit Polyclonal Antibody
Supplier: Invitrogen™ PA533561
Description
Percent identity with other species by BLAST analysis: Human, Monkey, Marmoset, Mouse, Rat, Panda, Opossum (100%).
Members of the Frizzled family encode seven-transmembrane domain proteins that are receptors for the Wingless type MMTV integration site family of signaling proteins. Most frizzled receptors are coupled to the beta-catenin canonical signaling pathway. Frizzled 8 is highly expressed in two human cancer cell lines, indicating that it may play a role in several types of cancer. Its expression has been reported in brain, heart, kidney, pancreas, and skeletal muscle. ESTs have been isolated from embryo, eye, head/neck, heart, kidney, liver/spleen, pancreas, prostate, and testis libraries, as well as many tumor libraries. The crystal structure of the extracellular cysteine-rich domain of a similar mouse protein has been determined.
Specifications
| FZD8 | |
| Polyclonal | |
| Unconjugated | |
| Fzd8 | |
| frizzled 8, seven transmembrane spanning receptor; frizzled class receptor 8; frizzled family receptor 8; frizzled homolog 8; frizzled homolog 8 (Drosophila); frizzled-8; Fz8; Fz-8; Fzd8; hFZ8; HGNC:4046 | |
| Rabbit | |
| Antigen Affinity Chromatography | |
| RUO | |
| 14370, 364754, 8325 | |
| Store at 4°C short term. For long term storage, store at -20°C, avoiding freeze/thaw cycles. | |
| Liquid |
| Immunohistochemistry (Paraffin) | |
| 1 mg/mL | |
| PBS with 0.1% sodium azide | |
| Q498S8, Q61091, Q9H461 | |
| Fzd8 | |
| Synthetic 15 amino acid peptide from N-terminal extracellular domain of human FZD8 / Frizzled 8. | |
| 50 μg | |
| Primary | |
| Human, Mouse, Rat, Monkey | |
| Antibody | |
| IgG |
Product Content Correction
Your input is important to us. Please complete this form to provide feedback related to the content on this product.
Product Title
Spot an opportunity for improvement?Share a Content Correction